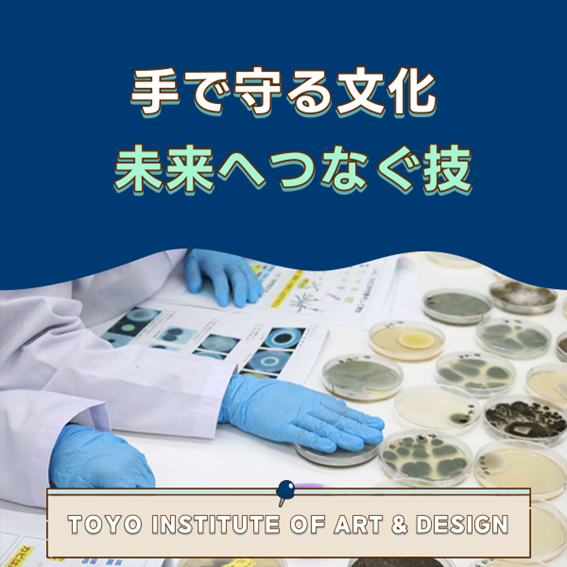
Picture1.png

【東洋美術学校】以技藝與學習 將時間連結至未來「保存修復科」
超越時間,與作品正面相對
寧靜的實習室中,
畫筆尖細緩地掠過微小的裂痕,
彷彿在確認埋藏於其下的「記憶」,
手便跟著微微動起。
在東洋美術學校的保存修復科,
學習的並不只是把損壞的物件「修好」,
而是掌握能讓作品所承載的時間
與人們的情感 「延續至未來」 的技術與心法。
面對的不是創造藝術,
而是「保存藝術」這另一種形態的美。
在這裡,你能獲得為此所需的
扎實學習與專業基礎。





由畢業生延續的「手的記憶」
保存修復科的畢業生,
活躍於博物館、美術館、文化財修復公司等
文化財修復的第一線。
其中備受矚目的油畫修復者 青山莉緒,
自本學科畢業後,
在攻讀研究所的同時,
也參與老化嚴重的「唐鈴神社」再生修復計畫。
「守護文化財,不只是把物品修好,
而是保存其中所承載的人的記憶。」
她的這句話中,
能感受到她在東洋美術學校所培養出的
「細緻觀察、用心動手」的態度。
從學生作品展看見「技術 × 藝術」
在學期間便擁有豐富的
實作與展示機會,
也是本科的大特色之一。
目前於日比谷圖書文化館舉辦的
「100 年後也能被取下翻閱的書──
內田嘉吉文庫修復報告 2025」
展出了保存修復科學生
於課堂中完成的西式裝幀修復作品。
本校在4年間能系統性地學習
六大領域的保存修復,
並可參與漫畫原畫保存計畫、
災害資料救援等
「與社會連結的修復實務經驗」。
學習的不只是「技術」,更是「心意」
保存修復科以繪畫、雕塑、
紙本資料、建具等多樣素材為對象,
從修復理論到技術操作,
循序漸進地學習。
1 年級: 保存修復的基礎理論與基本技術
2 年級: 以日本畫、油畫為主的修復實習
4 年級: 以掛軸、建具、版畫等
為主題的畢業研究
→ 最終成果將於畢業製作展公開
在實際接觸文化財的實習中,
教室裡瀰漫著筆、刮刀、膠劑的氣味,
學生們一邊記錄微小變化,
一邊專注地與作品對話。
「連看不見的地方也要做到細緻。」
這正是東洋美術學校最重視的精神所在。

以「雙手守護文化」的生活方式,
開啟未來職涯
校內設有修復實習室、畫廊館,
以及端硯展示等設施,
提供完善的環境支持學生的實作學習。
對留學生也非常友善,
不僅提供專業術語的日語支援,
還有學習文化背景的特別講座,
即使是第一次用日語學習的學生,
也能安心挑戰。
畢業後,學生可前往:
日本國內從事文化財修復或美術相關工作
母國參與文化遺產保護工作
成為 「將日本技術連結世界的人才」,
選擇十分廣泛。
此外,學生還可取得 「高度專門士」 稱號,
並可進一步挑戰 「學藝員」資格。
將守護文化的雙手交到你手中
文化財修復的工作,
不是守護「現在的美」,
而是守護「未來有人能觸摸的價值」。
如果你希望
「在日本親手接觸真正的文化財,學習修復技術」
「把守護文化的工作作為自己的職涯」
那麼,保存修復科的學習
將是你的可靠第一步。
用雙手、用觀察、用心意,
將文化延續到未來。
這裡擁有你所需要的環境與機會。
在東洋美術學校,
不只是「創造文化」,
還能掌握「保存文化」這種新的美的形式。
先從參加 開放校園,
踏出你的第一步吧。

體驗入學・學校說明會・平日個別商談
提供設計、插畫、3DCG、影像、漫畫、藝術等各種課程。
透過體驗,讓學生找到「未來的職業」。期待大家的參加!
詳細的學系情報請查看官方網頁!
https://www.to-bi.ac.jp/dept/cdc/
<2026年度留學生入學考試要項>
https://www.to-bi.ac.jp/international/

★申請從9月1日開始,
面試將在調整好教員和學生的日程後,
以線上方式(如果住在東京近郊則可親自到校)進行,
所需時間約15~20分鐘
(由1名學生與2~3名教員進行)。
★作品與作品集的提交
・提交作品或作品集的請使用PDF格式。
(提交方式另行通知)
・無論是數位作品還是傳統作品均可。
・提交時請明確標註創作年月、使用軟體及製作期間。
・提交的作品將不予退還,請注意。
點選圖片下載學校簡章>>
留言
登録されたコメントがありません。







